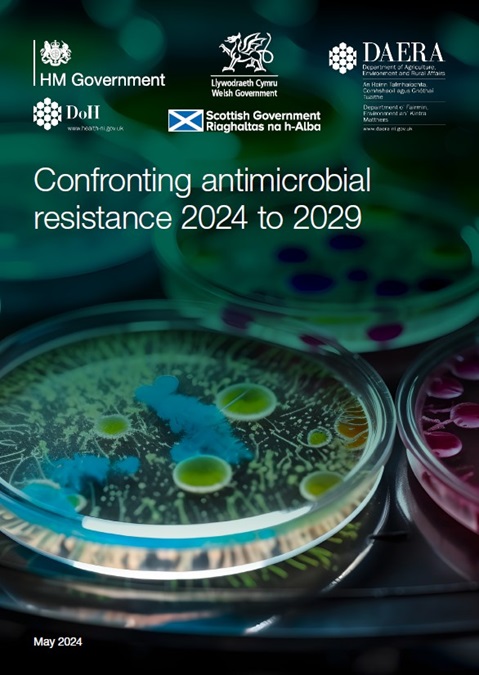

United Kingdom of Great Britain and Northern Ireland: Confronting antimicrobial resistance (2024-2029)
2024-2029
18 June 2024
| Publication
WHO Team
National Action Plans and Monitoring and Evaluation (NPM)
Number of pages
85
